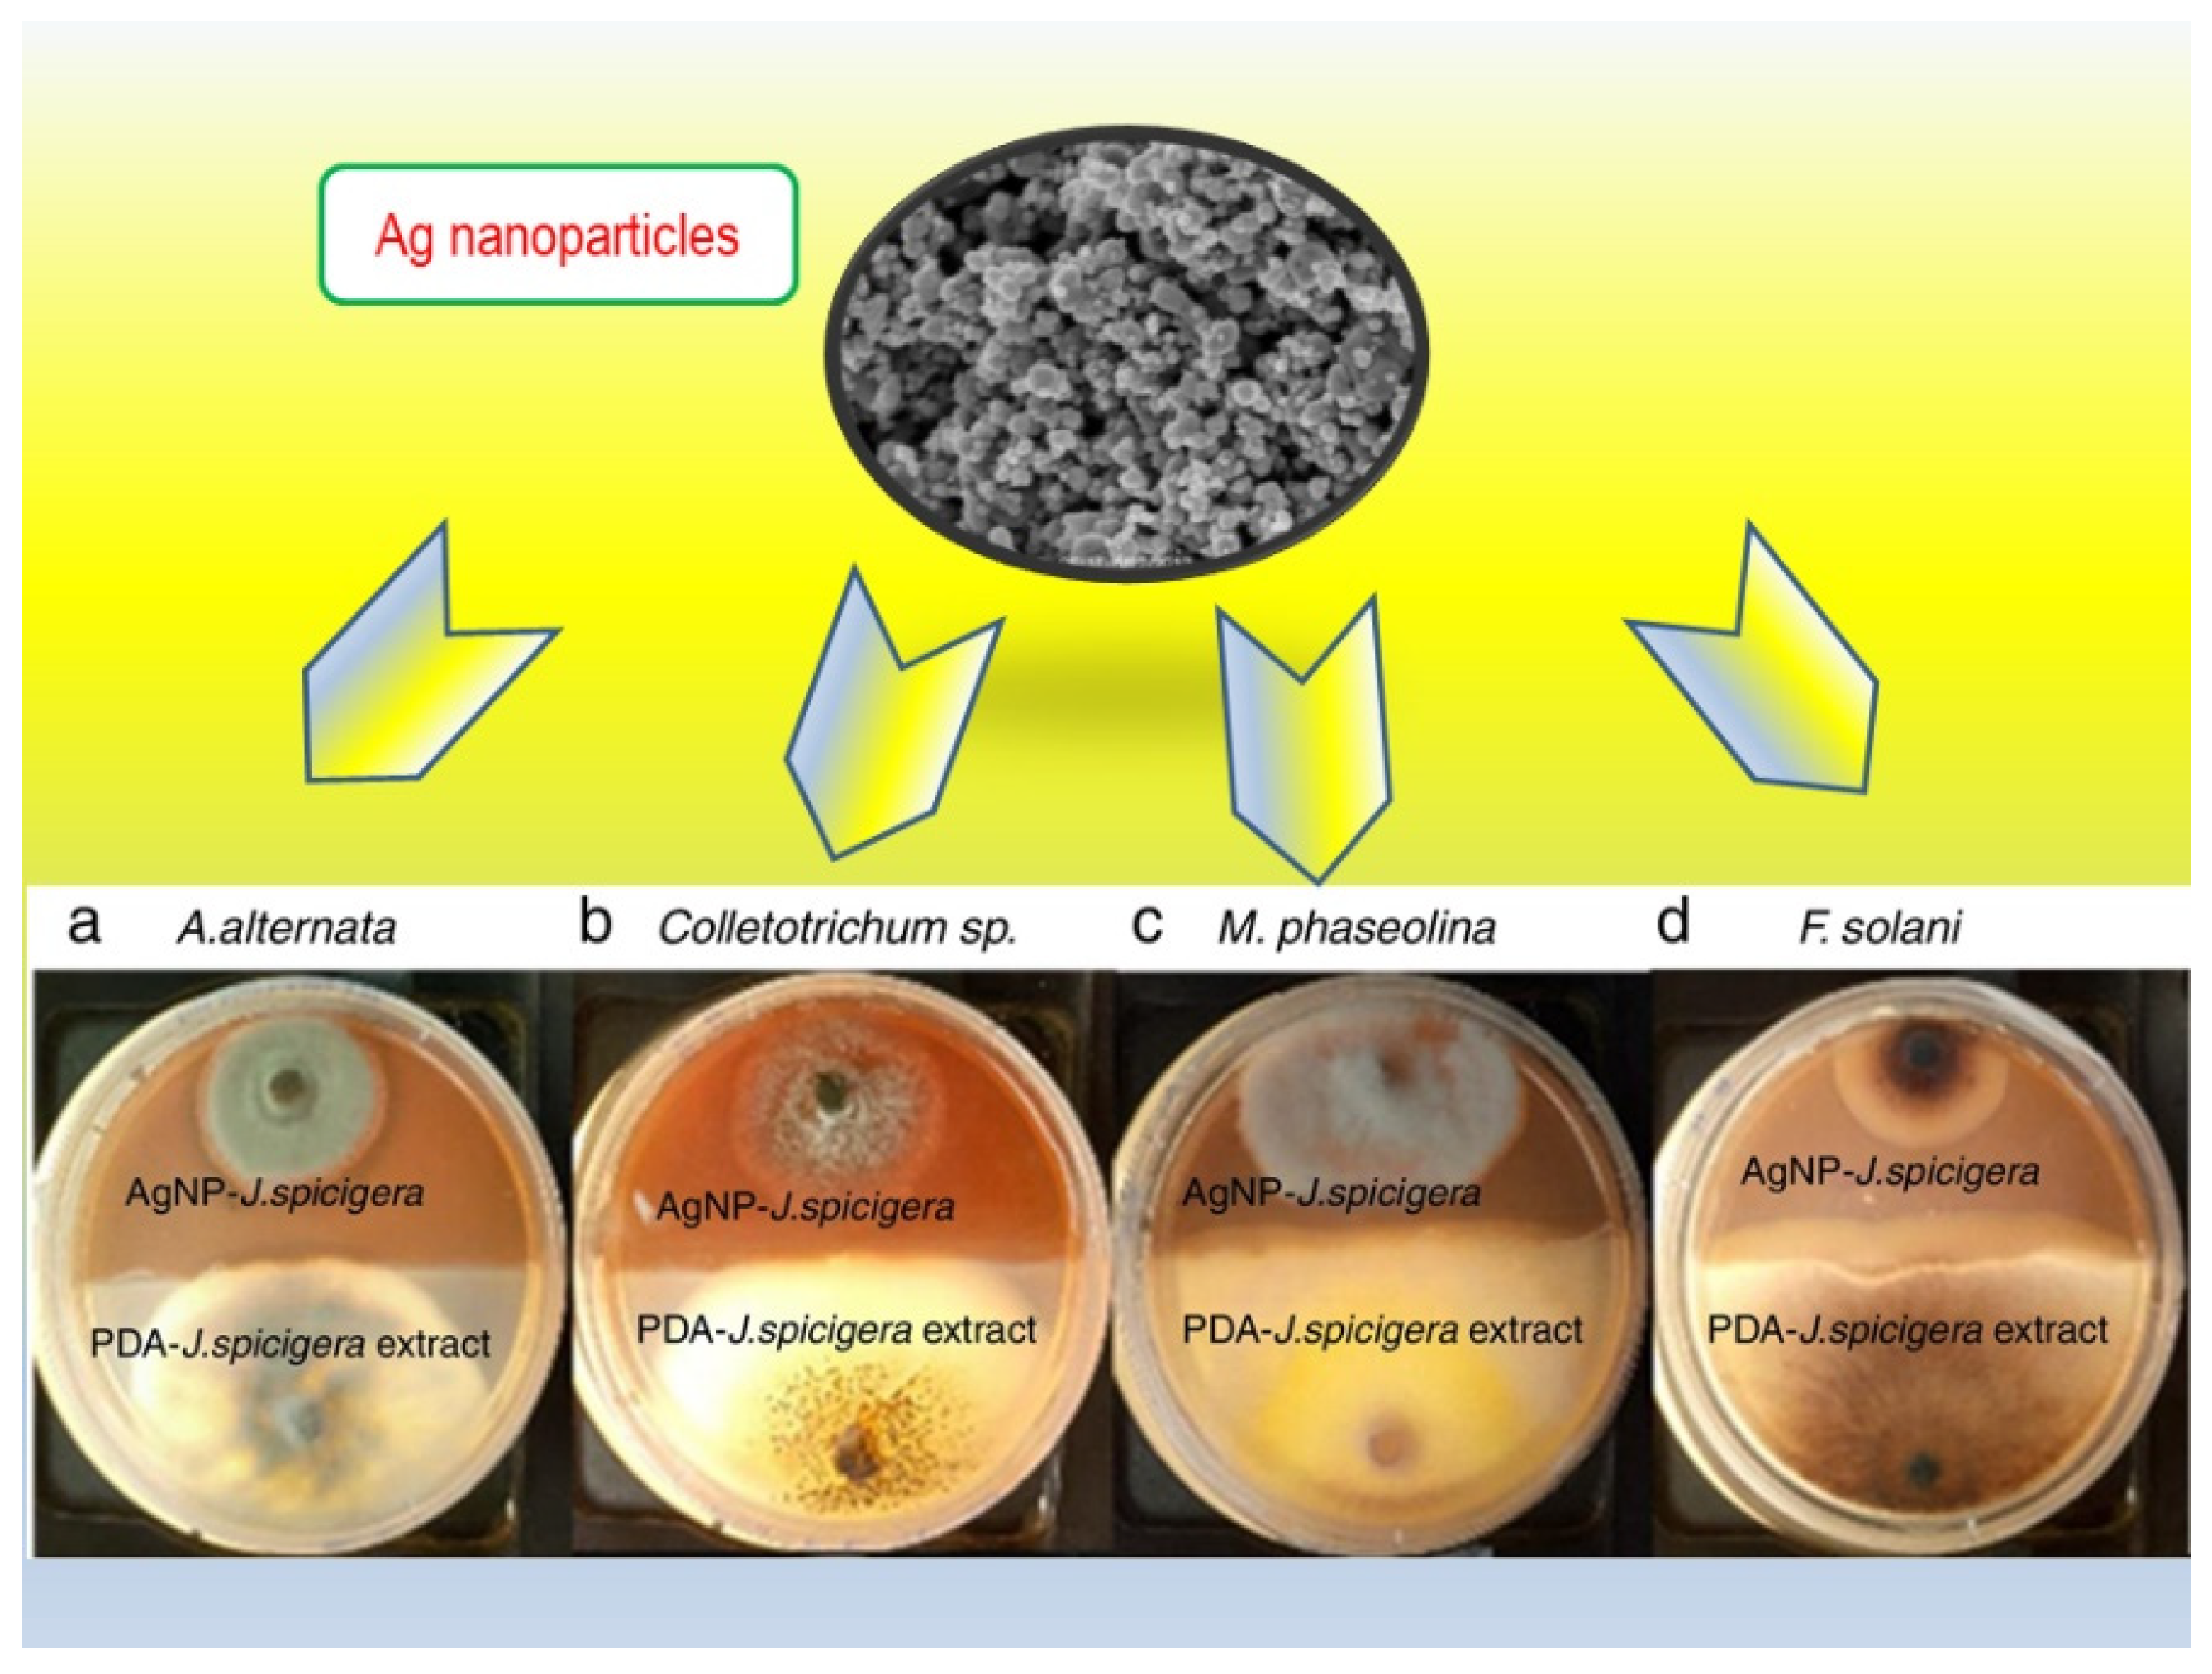

Beyond the Exploration of Muicle (Justicia spicigera): Reviewing Its Biological Properties, Bioactive Molecules and Materials Chemistry
Abstract
:1. Introduction
2. Towards the Identification and Related Biological Activities of Biomolecules Contained in Muicle (Justicia spicigera)
2.1. Anti-Diabetic Properties
2.2. Anti-Hypertensive Properties
2.3. Anti-Depressant and Antianxiety Properties
2.4. Anti-Cancer Properties
2.5. Anti-Oxidant Properties
2.6. Anti-Inflammatory, Anti-Obesity Properties and Other Health Benefits
3. Application of Muicle (J. spicigera) Biomolecules in Food and Bioproducts
4. Application of Muicle (J. spicigera) Biomolecules as Colorants and Synthesis of Materials
5. Concluding Remarks, Future Perspectives and Suggestions for the New Researchers in the Field
Author Contributions
Funding
Institutional Review Board Statement
Informed Consent Statement
Data Availability Statement
Acknowledgments
Conflicts of Interest
References
- Geck, M.S.; Cristians, S.; Berger-González, M.; Casu, L.; Heinrich, M.; Leonti, M. Traditional Herbal Medicine in Mesoamerica: Toward Its Evidence Base for Improving Universal Health Coverage. Front. Pharmacol. 2020, 11, 1160. [Google Scholar] [CrossRef] [PubMed]
- Alonso-Castro, A.J.; Maldonado-Miranda, J.J.; Zarate-Martinez, A.; Jacobo-Salcedo, M.D.R.; Fernández-Galicia, C.; Figueroa-Zuñiga, L.A.; Rios-Reyes, N.A.; de León-Rubio, M.A.; Medellín-Castillo, N.A.; Reyes-Munguia, A.; et al. Medicinal plants used in the Huasteca Potosina, México. J. Ethnopharmacol. 2012, 143, 292–298. [Google Scholar] [CrossRef] [PubMed]
- López-Rubalcava, C.; Estrada-Camarena, E. Mexican medicinal plants with anxiolytic or antidepressant activity: Focus on preclinical research. J. Ethnopharmacol. 2016, 186, 377–391. [Google Scholar] [CrossRef] [PubMed]
- Lin, D.; Xiao, M.; Zhao, J.; Li, Z.; Xing, B.; Li, X.; Kong, M.; Li, L.; Zhang, Q.; Liu, Y.; et al. An Overview of Plant Phenolic Compounds and Their Importance in Human Nutrition and Management of Type 2 Diabetes. Molecules 2016, 21, 1374. [Google Scholar] [CrossRef]
- Baqueiro-Peña, I.; Guerrero-Beltrán, J.A. Uses of Justicia spicigera in medicine and as a source of pigments. Funct. Foods Health Dis. 2014, 4, 401–414. [Google Scholar] [CrossRef]
- Vega-Avila, E.; Tapia-Aguilar, R.; Reyes-Chilpa, R.; Guzmán-Gutiérrez, S.L.; Pérez-Flores, J.; Velasco-Lezama, R. Actividad antibacteriana y antifúngica de Justicia spicigera. Rev. Latinoam. Quim. 2012, 40, 75–82. [Google Scholar]
- Ramírez, G.; Zavala, M.; Pérez, J.; Zamilpa, A. In VitroScreening of Medicinal Plants Used in Mexico as Antidiabetics with Glucosidase and Lipase Inhibitory Activities. Evid.-Based Complement. Altern. Med. 2012, 2012, 701261. [Google Scholar] [CrossRef] [Green Version]
- Ortiz-Andrade, R.; Cabañas-Wuan, A.; Argaez, V.E.A.; Alonso-Castro, A.J.; Zapata-Bustos, R.; Salazar-Olivo, L.A.; Dominguez, F.; Chávez, M.; Carranza-Álvarez, C.; García-Carrancá, A. Antidiabetic effects of Justicia spicigera Schltdl (Acanthaceae). J. Ethnopharmacol. 2012, 143, 455–462. [Google Scholar] [CrossRef]
- Euler, K.L.; Alam, M. Isolation of Kaempferitrin From Justicia spicigera. J. Nat. Prod. 1982, 45, 220–221. [Google Scholar] [CrossRef]
- Yadav, N.; Vasudeva, N.; Singh, S.; Sharma, S.K. Medicinal properties of genus Chenopodium linn. Indian J. Nat. Prod. Resour. 2007, 6, 131–134. [Google Scholar]
- Esquivel-Gutiérrez, E.R.; Noriega-Cisneros, R.; AreIIano-PIaza, M.; Ibarra-Barajas, M.; Salgado-Garciglia, R.; Saave-dra-Molina, A. Antihypertensive effect of Justicia spicigera in L-NAME-induced hypertensive rats. Pharmacologyonline 2013, 2, 120–127. [Google Scholar]
- Dominguez, X.A.; Achenbach, H.; Gonzalez, C.; Ferre-D’Amare, A. Estudio Químico del “Muitle” (Justicia spicigera). Rev. Latinoam. Quim. 1990, 21, 142–143. [Google Scholar]
- MagosGuerrero, G.; SantiagoMeja, J.; Carrasco, O. Exploratory studies of some Mexican medicinal plants. Cardiovascular effects in rats with and without hypertension. J. Intercult. Ethnopharmacol. 2017, 6, 274–279. [Google Scholar] [CrossRef] [PubMed]
- Cassani, J.; Dorantes-Barrón, A.M.; Novales, L.M.; Real, G.A.; Estrada-Reyes, R. Anti-Depressant-Like Effect of Kaempferitrin Isolated from Justicia spicigera Schltdl (Acanthaceae) in Two Behavior Models in Mice: Evidence for the Involvement of the Serotonergic System. Molecules 2014, 19, 21442–21461. [Google Scholar] [CrossRef] [PubMed] [Green Version]
- García-Ríos, R.I.; Mora-Pérez, A.; González-Torres, D.; Carpio-Reyes, R.D.J.; Soria-Fregozo, C. Anxiolytic-like effect of the aqueous extract of Justicia spicigera leaves on female rats: A comparison to diazepam. Phytomedicine 2019, 55, 9–13. [Google Scholar] [CrossRef]
- Alonso-Castro, A.J.; Ortiz-Sánchez, E.; Domínguez, F.; Arana-Argáez, V.; Juárez-Vázquez, M.D.C.; Chávez, M.; Carranza-Álvarez, C.; Gaspar-Ramírez, O.; Espinosa-Reyes, G.; López-Toledo, G.; et al. Antitumor and immunomodulatory effects of Justicia spicigera Schltdl (Acanthaceae). J. Ethnopharmacol. 2012, 141, 888–894. [Google Scholar] [CrossRef]
- Alonso-Castro, A.J.; Ortiz-Sánchez, E.; García-Regalado, A.; Ruiz, G.; Núñez-Martínez, J.M.; González-Sánchez, I.; Quintanar-Jurado, V.; Morales-Sánchez, E.; Dominguez, F.; López-Toledo, G.; et al. Kaempferitrin induces apoptosis via intrinsic pathway in HeLa cells and exerts antitumor effects. J. Ethnopharmacol. 2013, 145, 476–489. [Google Scholar] [CrossRef]
- Juárez-Vázquez, M.D.C.; Alonso-Castro, A.J.; García-Carrancá, A. Kaempferitrin induces immunostimulatory effects in vitro. J. Ethnopharmacol. 2013, 148, 337–340. [Google Scholar] [CrossRef]
- Fernández-Pomares, C.; Juárez-Aguilar, E.; Domínguez-Ortiz, M.; Gallegos-Estudillo, J.; Herrera-Covarrubias, D.; Sánchez-Medina, A.; Aranda-Abreu, G.E.; Manzo, J.; Hernández, M.E. Hydroalcoholic extract of the widely used Mexican plant Justicia spicigera Schltdl. exerts a cytostatic effect on LNCaP prostate cancer cells. J. Herb. Med. 2018, 12, 66–72. [Google Scholar] [CrossRef]
- Jacobo-Salcedo, M.D.R.; Alonso-Castro, A.J.; Salazar-Olivo, L.A.; Carranza-Alvarez, C.; Gonzaĺez-Espińdola, L.A.; Domińguez, F.; Maciel-Torres, S.P.; Garciá-Lujan, C.; Gonzaĺez-Martińez, M.D.R.; Goḿez-Sańchez, M.; et al. Antimicrobial and cytotoxic effects of Mexican medicinal plants. Nat. Prod. Commun. 2011, 6, 1925–1928. [Google Scholar] [CrossRef] [Green Version]
- García-Márquez, E.; Román-Guerrero, A.; Pérez-Alonso, C.; Cruz-Sosa, F.; Jiménez-Alvarado, R.; Vernon-Carter, E.J. Effect of solvent-temperature extraction conditions on the initial antioxidant activity and total phenolic content of muitle extracts and their decay upon storage at different pH. Rev. Mex. Ing. Química 2012, 11, 1–10. [Google Scholar]
- Anaya-Esparza, L.M.; Ramos-Aguirre, D.; Zamora-Gasga, V.M.; Yahia, E.; Montalvo-González, E. Optimization of ultrasonic-assisted extraction of phenolic compounds from Justicia spicigera leaves. Food Sci. Biotechnol. 2018, 27, 1093–1102. [Google Scholar] [CrossRef] [PubMed]
- Martinez-Morales, F.; Alonso-Castro, A.J.; Zapata-Morales, J.R.; Carranza-Álvarez, C.; Aragon-Martinez, O.H. Use of standardized units for a correct interpretation of IC50 values obtained from the inhibition of the DPPH radical by natural antioxidants. Chem. Pap. 2020, 74, 3325–3334. [Google Scholar] [CrossRef]
- Awad, N.E.; Abdelkawy, M.A.; Hamed, M.A.; Souleman, A.M.A.; Abdelrahman, E.H.; Ramadan, N.S. Anti-oxidant and hepatoprotective effects of Justicia spicigera ethyl acetate fraction and characterization of its anthocyanin con-tent. Int. J. Pharm. Pharm. Sci. 2015, 7, 91–96. [Google Scholar]
- Awad, N.E.; Abdelkawy, M.A.; Rahman, E.H.A.; Hamed, M.A.; Ramadan, N.S. Phytochemical and in vitro Screening of Justicia spicigera Ethanol Extract for Antioxidant Activity and in vivo Assessment Against Schistosoma mansoni Infection in Mice. Anti-Infect. Agents 2018, 16, 49–56. [Google Scholar] [CrossRef]
- Real-Sandoval, S.A.; Gutiérrez-López, G.F.; Domínguez-López, A.; Paniagua-Castro, N.; Michicotl-Meneses, M.M.; Jaramillo-Flores, M.E. Downregulation of proinflammatory liver gene expression by Justicia spicigera and kaempferitrin in a murine model of obesity-induced by a high-fat diet. J. Funct. Foods 2020, 65, 103781. [Google Scholar] [CrossRef]
- Zapata-Morales, J.R.; Alonso-Castro, A.J.; Domínguez, F.; Carranza-Álvarez, C.; Castellanos, L.M.O.; Martínez-Medina, R.M.; Pérez-Urizar, J. Antinociceptive Activity of an Ethanol Extract of Justicia spicigera. Drug Dev. Res. 2016, 77, 180–186. [Google Scholar] [CrossRef]
- Ángeles-López, G.E.; González-Trujano, M.E.; Rodríguez, R.; Déciga-Campos, M.; Brindis, F.; Ventura-Martínez, R. Gastrointestinal activity of Justicia spicigera Schltdl. in experimental models. Nat. Prod. Res. 2021, 35, 1847–1851. [Google Scholar] [CrossRef]
- González-Trujano, M.E.; Domínguez, F.; Pérez-Ortega, G.; Aguillón, M.; Martínez-Vargas, D.; Almazán-Alvarado, S.; Martínez, A. Justicia spicigera Schltdl. and kaempferitrin as potential anticonvulsant natural products. Biomed. Pharmacother. 2017, 92, 240–248. [Google Scholar] [CrossRef]
- Weng, J.-R.; Ko, H.-H.; Yeh, T.-L.; Lin, H.-C.; Lin, C.-N. Two New Arylnaphthalide Lignans and Antiplatelet Constituents from Justicia procumbens. Arch. Pharm. 2004, 337, 207–212. [Google Scholar] [CrossRef]
- Gutierrez, R.M.P.; Flores, J.M.M.; Gonzalez, A.M.N. Anti-inflammatory effect of procumbenoside B from Justicia spicigera on lipopolysaccharide-stimulated RAW 264.7 macrophages and zebrafish model. Pharmacogn. Res. 2018, 10, 218–224. [Google Scholar] [CrossRef]
- Valencia-Arredondo, J.A.; Hernández-Bolio, G.I.; Cerón-Montes, G.I.; Castro-Muñoz, R.; Yáñez-Fernández, J. Enhanced process integration for the extraction, concentration and purification of di-acylated cyanidin from red cabbage. Sep. Purif. Technol. 2020, 238, 116492. [Google Scholar] [CrossRef]
- Arberet, L.; Pottier, F.; Michelin, A.; Nowik, W.; Bellot-Gurlet, L.; Andraud, C. Spectral characterisation of a traditional Mesoamerican dye: Relationship between in situ identification on the 16th century Codex Borbonicus manuscript and composition of Justicia spicigera plant extract. Analyst 2021, 146, 2520–2530. [Google Scholar] [CrossRef] [PubMed]
- Baqueiro-Peña, I.; Guerrero-Beltrán, J. Physicochemical and antioxidant characterization of Justicia spicigera. Food Chem. 2017, 218, 305–312. [Google Scholar] [CrossRef] [PubMed]
- Pavón-García, L.M.A.; Pérez-Alonso, C.; Orozco-Villafuerte, J.; Pimentel-González, D.J.; Huezo, M.E.R.; Vernon-Carter, E.J. Storage stability of the natural colourant from Justicia spicigera microencapsulated in protective colloids blends by spray-drying. Int. J. Food Sci. Technol. 2011, 46, 1428–1437. [Google Scholar] [CrossRef]
- Castro-Alatorre, N.; Gallardo-Velázquez, T.; Boyano-Orozco, L.; Téllez-Medina, D.; Meza-Márquez, O.; Osorio-Revilla, G. Extraction and Microencapsulation of Bioactive Compounds from Muicle (Justicia spicigera) and Their Use in the Formulation of Functional Foods. Foods 2021, 10, 1747. [Google Scholar] [CrossRef]
- Alvarez-Poblano, L.; Roman-Guerrero, A.; Vernon-Carter, E.; Alvarez-Ramirez, J. Exogenous addition of muicle (Justicia spicigera Schechtendal) extract to white maize tortillas affects the antioxidant activity, texture, color, and in vitro starch digestibility. LWT 2020, 133, 110120. [Google Scholar] [CrossRef]
- Chan-Bacab, M.J.; Sanmartín, P.; Camacho-Chab, J.C.; Palomo-Ascanio, K.B.; Huitz-Quimé, H.E.; Ortega-Morales, B.O. Characterization and dyeing potential of colorant-bearing plants of the Mayan area in Yucatan Peninsula, Mexico. J. Clean. Prod. 2015, 91, 191–200. [Google Scholar] [CrossRef]
- Bernardo-Mazariegos, E.; Valdez-Salas, B.; González-Mendoza, D.; Abdelmoteleb, A.; Camacho, O.T.; Duran, C.C.; Gutiérrez-Miceli, F. Silver nanoparticles from Justicia spicigera and their antimicrobial potentialities in the biocontrol of foodborne bacteria and phytopathogenic fungi. Rev. Argent. Microbiol. 2019, 51, 103–109. [Google Scholar] [CrossRef]
- Abbaszadegan, A.; Ghahramani, Y.; Gholami, A.; Hemmateenejad, B.; Dorostkar, S.; Nabavizadeh, M.; Sharghi, H. The effect of charge at the surface of silver nanoparticles on antimicrobial activity against gram-positive and gram-negative bacteria: A preliminary study. J. Nanomater. 2015, 48, 53. [Google Scholar] [CrossRef] [Green Version]
- Castro-Muñoz, R. The Role of New Inorganic Materials in Composite Membranes for Water Disinfection. Membranes 2020, 10, 101. [Google Scholar] [CrossRef] [PubMed]
- Wei, L.; Lu, J.; Xu, H.; Patel, A.; Chen, Z.-S.; Chen, G. Silver nanoparticles: Synthesis, properties, and therapeutic applications. Drug Discov. Today 2015, 20, 595–601. [Google Scholar] [CrossRef] [PubMed] [Green Version]
- Gonzalez-Mendoza, D.; Valdez-Salas, B.; Bernardo-Mazariegos, E.; Camacho, O.T.; Gutiérrez-Miceli, F.; Ruíz-Valdiviezo, V.; Rodríguez-Hernández, L.; Sanchez-Viveros, G. Influence of monometallic and bimetallic phytonanoparticles on physiological status of mezquite. Open Life Sci. 2019, 14, 62–68. [Google Scholar] [CrossRef]
- Ruíz-Baltazar, D.J. Green synthesis assisted by sonochemical activation of Fe3O4-Ag nano-alloys: Structural characterization and studies of sorption of cationic dyes. Inorg. Chem. Commun. 2020, 120, 108148. [Google Scholar] [CrossRef]
- Anastas, P.T.; Eghbali, N. Green Chesmitry: Principles and Practice. Chem. Soc. Rev. 2010, 39, 201–312. [Google Scholar] [CrossRef] [PubMed]
- Soto-Robles, C.; Nava, O.; Cornejo, L.; Lugo, E.; Vilchis-Nestor, A.; Castro-Beltrán, A.; Luque, P. Biosynthesis, characterization and photocatalytic activity of ZnO nanoparticles using extracts of Justicia spicigera for the degradation of methylene blue. J. Mol. Struct. 2021, 1225, 129101. [Google Scholar] [CrossRef]
- Duan, H.; Wang, D.; Li, Y. Green chemistry for nanoparticle synthesis. Chem. Soc. Rev. 2015, 44, 5778–5792. [Google Scholar] [CrossRef]
- Castro-Muñoz, R.; González-Melgoza, L.L.; García-Depraect, O. Ongoing progress on novel nanocomposite membranes for the separation of heavy metals from contaminated water. Chemosphere 2021, 270, 129421. [Google Scholar] [CrossRef]
- Serna-Vázquez, J.; Ahmad, M.Z.; Boczkaj, G.; Castro-Muñoz, R. Latest Insights on Novel Deep Eutectic Solvents (DES) for Sustainable Extraction of Phenolic Compounds from Natural Sources. Molecules 2021, 26, 5037. [Google Scholar] [CrossRef]
- Cienfuegos, N.; Santos, P.; García, A.; Soares, C.; Lima, A.; Souza, R. Integrated process for purification of capsaicin using aqueous two-phase systems based on ethanol. Food Bioprod. Process. 2017, 106, 1–10. [Google Scholar] [CrossRef]
- Lama-Muñoz, A.; Contreras, M.D.M.; Espínola, F.; Moya, M.; de Torres, A.; Romero, I.; Castro, E. Extraction of oleuropein and luteolin-7-O-glucoside from olive leaves: Optimization of technique and operating conditions. Food Chem. 2019, 293, 161–168. [Google Scholar] [CrossRef] [PubMed]
- Ferrentino, G.; Morozova, K.; Mosibo, O.K.; Ramezani, M.; Scampicchio, M. Biorecovery of antioxidants from apple pomace by supercritical fluid extraction. J. Clean. Prod. 2018, 186, 253–261. [Google Scholar] [CrossRef]
- Yan, L.-G.; Deng, Y.; Ju, T.; Wu, K.; Xi, J. Continuous high voltage electrical discharge extraction of flavonoids from peanut shells based on “annular gap type” treatment chamber. Food Chem. 2018, 256, 350–357. [Google Scholar] [CrossRef] [PubMed]
- Castro-Muñoz, R.; Boczkaj, G.; Gontarek, E.; Cassano, A.; Fíla, V. Membrane technologies assisting plant-based and agro-food by-products processing: A comprehensive review. Trends Food Sci. Technol. 2020, 95, 219–232. [Google Scholar] [CrossRef]

Publisher’s Note: MDPI stays neutral with regard to jurisdictional claims in published maps and institutional affiliations. |
© 2022 by the authors. Licensee MDPI, Basel, Switzerland. This article is an open access article distributed under the terms and conditions of the Creative Commons Attribution (CC BY) license (https://creativecommons.org/licenses/by/4.0/).
Share and Cite
Castro-Muñoz, R.; León-Becerril, E.; García-Depraect, O. Beyond the Exploration of Muicle (Justicia spicigera): Reviewing Its Biological Properties, Bioactive Molecules and Materials Chemistry. Processes 2022, 10, 1035. https://doi.org/10.3390/pr10051035
Castro-Muñoz R, León-Becerril E, García-Depraect O. Beyond the Exploration of Muicle (Justicia spicigera): Reviewing Its Biological Properties, Bioactive Molecules and Materials Chemistry. Processes. 2022; 10(5):1035. https://doi.org/10.3390/pr10051035
Chicago/Turabian StyleCastro-Muñoz, Roberto, Elizabeth León-Becerril, and Octavio García-Depraect. 2022. "Beyond the Exploration of Muicle (Justicia spicigera): Reviewing Its Biological Properties, Bioactive Molecules and Materials Chemistry" Processes 10, no. 5: 1035. https://doi.org/10.3390/pr10051035
APA StyleCastro-Muñoz, R., León-Becerril, E., & García-Depraect, O. (2022). Beyond the Exploration of Muicle (Justicia spicigera): Reviewing Its Biological Properties, Bioactive Molecules and Materials Chemistry. Processes, 10(5), 1035. https://doi.org/10.3390/pr10051035

